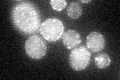
YIL105C
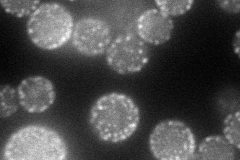
YIL105C
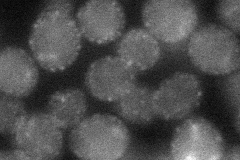
YIL105C
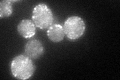
YIL105C
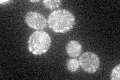
YIL105C

View description
Phosphoinositide PI4,5P(2) binding protein, forms a complex with Slm2p; acts downstream of Mss4p in a pathway regulating actin cytoskeleton organization in response to stress; phosphorylated by the TORC2 complex
Localization:
Intensity:
Fold change:
Significance:
-
C’ GFP library in SD
punctate37.4 -
N' NOP1pr-GFP in SD
cell periphery,punctate63.2395 -
N' TEF2pr-mCherry in SD

cell periphery,punctate70.4666 -
N' NATIVEpr-GFP in SD

punctate27.6524 -
N' TEF2pr-VC and Cyto-VN in SD
cell periphery,punctate35.8192 -
C’ GFP library in SD+DTT
punctate45.381.21No -
C’ GFP library in SD+H2O2

punctate45.051.2No -
C’ GFP library in Starvation Media
punctate38.71.03No -
C’ GFP library on the background of Pup2-DaMP

punctate -
C’ GFP library on the background of CCT mutant

punctate38.87631.03904No
